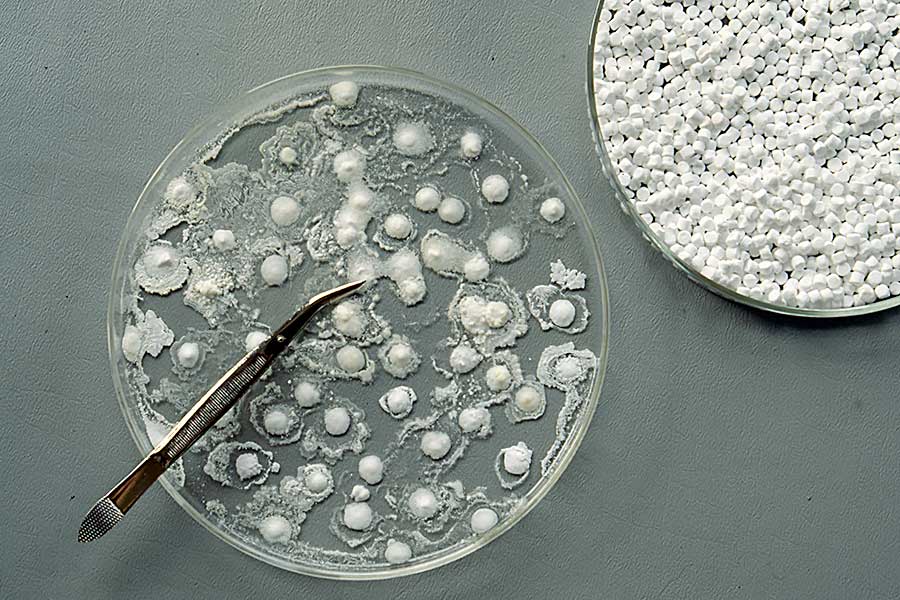

© 2015

One Hundred Links (for Rousseau)
neurotransmitters, sugar tabs, scientific glassware, table
42" x 24" x 20"
1992
Jean-Jacques Rousseau opens The Social Contract with: "Man is born free, and everywhere he is in chains. Those who think themselves the masters of others are indeed greater slaves than they."
In contemporary society, the chains that bind us to civilization are often seen as neurochemical, and the cure can be found in altering that chemistry. Visitors are invited to experience one hundred states of mind – each a link in the chain – derived from literature, folklore, and the psychopharmaceutical industry.